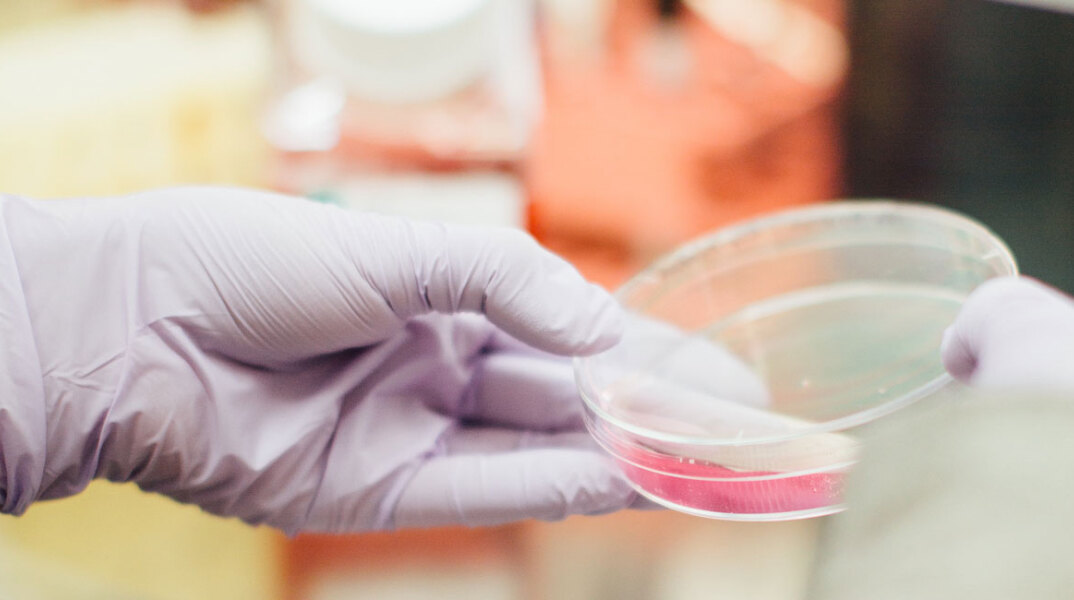
cell.jpg

- CITY GUIDE
- PODCAST
-
 17°
17°
Ο πρώτος μίνι τεχνητός ανθρώπινος οισοφάγος είναι γεγονός
Σπουδαίο ιατρικό επίτευγμα

Επιστήμονες στις ΗΠΑ, που εργάζονται για να αναδημιουργήσουν με μεθόδους εμβιομηχανικής στο εργαστήριο όλο το ανθρώπινο γαστρεντερικό σύστημα, ανακοίνωσαν ότι πέτυχαν να αναπτύξουν ιστό ανθρώπινου οισοφάγου μέσω της καλλιέργειας πολυδύναμων βλαστικών κυττάρων.
Η δημιουργία εργαστηριακού οισοφάγου θα δώσει στο μέλλον νέες διαγνωστικές και θεραπευτικές επιλογές στους γιατρούς για τους ασθενείς που πάσχουν από διαταραχές του οισοφάγου, κάνοντας πρόοδο στο πεδίο της εξατομικευμένης ιατρικής, προσαρμόζοντας δηλαδή την εκάστοτε θεραπεία στις ανάγκες κάθε ασθενούς.
Είναι η πρώτη φορά που οι επιστήμονες κατάφεραν να καλλιεργήσουν και να αναπτύξουν ιστό ανθρώπινου οισοφάγου αποκλειστικά από πολυδύναμα βλαστικά κύτταρα, τα οποία έχουν ήδη χρησιμοποιηθεί για την ανάπτυξη άλλων εργαστηριακών οργάνων (εντέρου, στομάχου, ήπατος).
Οι ερευνητές, με επικεφαλής τον Τζιμ Ουέλς του Ιατρικού Κέντρου του Νοσκομείου Παίδων του Σινσινάτι, έκαναν τη σχετική δημοσίευση στο περιοδικό βιολογίας "Cell Stem Cell".
Ο οισοφάγος μπορεί να εμφανίσει εκ γενετής παθήσεις (όπως η ατρησία που προκαλεί μια στένωση ή παραμόρφωσή του λόγω γενετικών μεταλλάξεων) ή διαταραχές που εκδηλώνονται αργότερα στη διάρκεια της ζωής του ασθενούς, όπως ο οισοφαγικός καρκίνος, η γαστροοισοφαγική παλινδρόμηση κ.α. Για όλες αυτές τις παθήσεις αναζητούνται καλύτερες θεραπείες από τις υπάρχουσες σήμερα.
Προς το παρόν πάντως, έχει αναπτυχθεί μόνο ένα «οργανοειδές» οισοφάγου. Θα χρειασθεί αρκετός ακόμη χρόνος για την εργαστηριακή δημιουργία ενός ολοκληρωμένου οισοφάγου.
Πηγή: ΑΠΕ-ΜΠΕ
ΤΑ ΠΙΟ ΔΗΜΟΦΙΛΗ

ΔΙΑΒΑΖΟΝΤΑΙ ΠΑΝΤΑ
ΔΕΙΤΕ ΕΠΙΣΗΣ
Η ιδανική διάρκεια για μυϊκή ενδυνάμωση - Τα τεράστια οφέλη της όταν συνδυάζεται με αερόβια άσκηση
Από τις κλινικές γονιμότητας μέχρι τις αποτυχημένες προσπάθειες, η εμπειρία ενός άνδρα μέσα στην εξωσωματική
Το watersport που σε κάνει να ξεχνάς ότι βρίσκεσαι ακόμα στην πόλη
Μιλήσαμε με τη δημιουργό και διοργανώτρια του project για το wellness trend που φέρνει το pilates στον ιππικό όμιλο Σείριος στο Κορωπί
Ο πιο αποτελεσματικός τρόπος που προτείνουν ειδικοί
Ένα μικρό βήμα που πολλές γυναίκες αγνοούν
Εμφανίζεται συχνότερα στους άνδρες, αλλά μπορεί να παρουσιαστεί και στις γυναίκες, καθώς και σε παιδιά ή βρέφη
Τα εύθραυστα νύχια μπορεί να είναι παχιά και εύθρυπτα ή μαλακά και εύκαμπτα
«Η έγκαιρη διάγνωση μπορεί να σώσει τη ζωή σου»!
Διακρίθηκαν οι φαρμακοβιομηχανίες UNI-PHARMA και InterMed
Επόμενος σταθμός η Λήμνος
Βοηθά η άσκηση με αντιστάσεις στον περιορισμό της εξέλιξής της;
Το εύρημα που εντυπωσίασε τους επιστήμονες
Εντυπωσιακά τα αποτελέσματα
Ένα επεισόδιο για τους φόβους που μας προστατεύουν, για εκείνους (τις φοβίες) που μας φυλακίζουν και για τη στιγμή που αρχίζουμε να αναρωτιόμαστε όχι «πώς θα σταματήσω να φοβάμαι», αλλά «τι είναι αυτό που φοβάται μέσα μου;».
Νοσηλεύτρια του Ερυθρού Σταυρού εξηγεί τι τελικά ισχύει με το συγκεκριμένο ψάρι
Το ενδιαφέρον των επιστημόνων στρέφεται πλέον και στις γυναίκες που δεν θηλάζουν
Πώς οι επιπτώσεις της ακραίας ζέστης δεν περιορίζονται στην ατομική δυσφορία, αλλά επεκτείνονται στην εργασία, τη μάθηση και στην ευρύτερη λειτουργία της κοινωνίας.
Τα πρώτα συμπτώματα και οι τρόποι αντιμετώπισης
Επιπλέον, μπορούν να καταγράψουν τη βλάβη που έχει συσσωρευτεί με την πάροδο των ετών
Έχετε δει 20 από 200 άρθρα.





















































